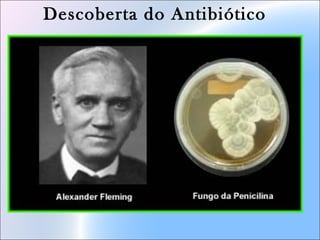
Descoberta do Antibiótico
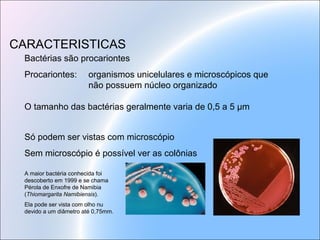
Bactérias são procariontes
Procariontes: organismos unicelulares e microscópicos que
não possuem núcleo organizado
O tamanho das bactérias geralmente varia de 0,5 a 5 μm
Só podem ser vistas com microscópio
Sem microscópio é possível ver as colônias
CARACTERISTICAS
A maior bactéria conhecida foi
descoberto em 1999 e se chama
Pérola de Enxofre de Namibia
(Thiomargarita Namibiensis).
Ela pode ser vista com olho nu
devido a um diâmetro até 0,75mm.
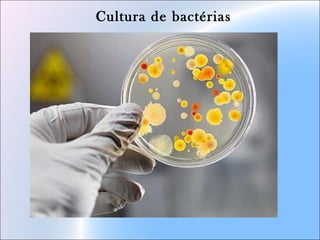
Cultura de bactérias
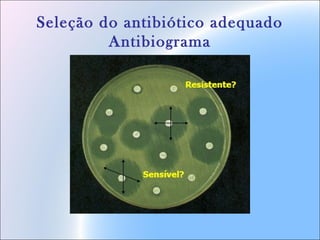
Seleção do antibiótico adequado
Antibiograma

O documento discute antibióticos e problemas relacionados a seu uso. Apresenta glossário de termos como agente etiológico, hospedeiro e parasita. Também descreve conceitos como antibiose, amensalismo e relações ecológicas. Aborda ainda resistência bacteriana, mecanismos como conjugação e formas de preveni-la.